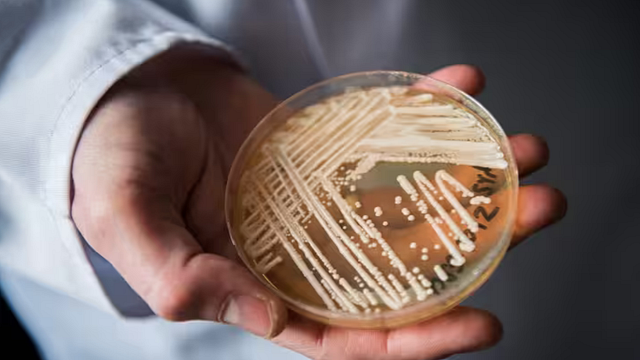

Un uomo che era stato contagiato dalla Candida auris - il cosiddetto "fungo killer" - è morto a Milano. L'uomo era stato infettato mentre si trovava in Grecia. Era stato ricoverato da alcuni giorni all'ospedale Sacco per un ictus. Gli esami di laboratorio a cui era sottoposto avevano evidenziato diverse positività, tra cui quella al fungo. Essendo appena rientrato dalla Grecia, non sarebbe un caso autoctono ma importato.
Cos'è la candida auris -
"La Candida auris è un fungo isolato per la prima volta nel 2009 in Giappone dall’orecchio (in latino “auris”) di una donna e si è poi diffuso in diversi Paesi del mondo. In Italia, il primo caso di infezione invasiva è stato identificato nel 2019 seguito da un focolaio nelle Regioni settentrionali nel biennio 2020-2021", si legge sul sito Epicentro dell'Istituto superiore di sanità (Iss). "Dal 2019 sono stati descritti e/o notificati sia casi importati che casi autoctoni per un totale di circa 300 casi in un focolaio epidemico che ha coinvolto principalmente Liguria ed Emilia Romagna".
Sintomi e trasmissione -
Le infezioni da Candida auris sono tipicamente accompagnate da bruciore, difficoltà a deglutire, dolori muscolari, febbre e affaticamento. Occorre segnalare che la cute e altri siti corporei possono essere colonizzati anche in assenza di segni e sintomi. Il fungo può trasmettersi attraverso il contatto con superfici e/o dispositivi medici contaminati o il contatto tra persone colonizzate o infette.